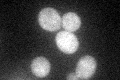
YLL038C
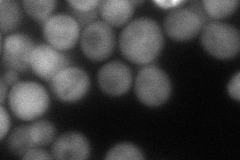
YLL038C
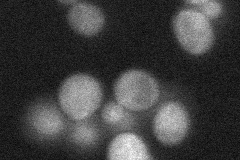
YLL038C
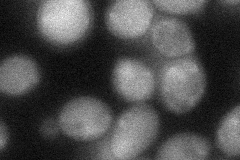
YLL038C
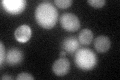
YLL038C

View description
Protein of unknown function, contains an N-terminal epsin-like domain; proposed to be involved in the trafficking of Arn1p in the absence of ferrichrome
Localization:
Intensity:
Fold change:
Significance:
-
C’ GFP library in SD
cytosol42.64 -
N' NOP1pr-GFP in SD

cytosol43.0696 -
N' TEF2pr-mCherry in SD
cytosol68.051 -
N' NATIVEpr-GFP in SD
cytosol28.4535 -
N' TEF2pr-VC and Cyto-VN in SD
cytosol39.4258 -
C’ GFP library in SD+DTT
cytosol38.230.89No -
C’ GFP library in SD+H2O2

cytosol34.140.8No -
C’ GFP library in Starvation Media

cytosol33.230.77No -
C’ GFP library on the background of Pup2-DaMP

cytosol -
C’ GFP library on the background of CCT mutant

cytosol43.98161.03125No
